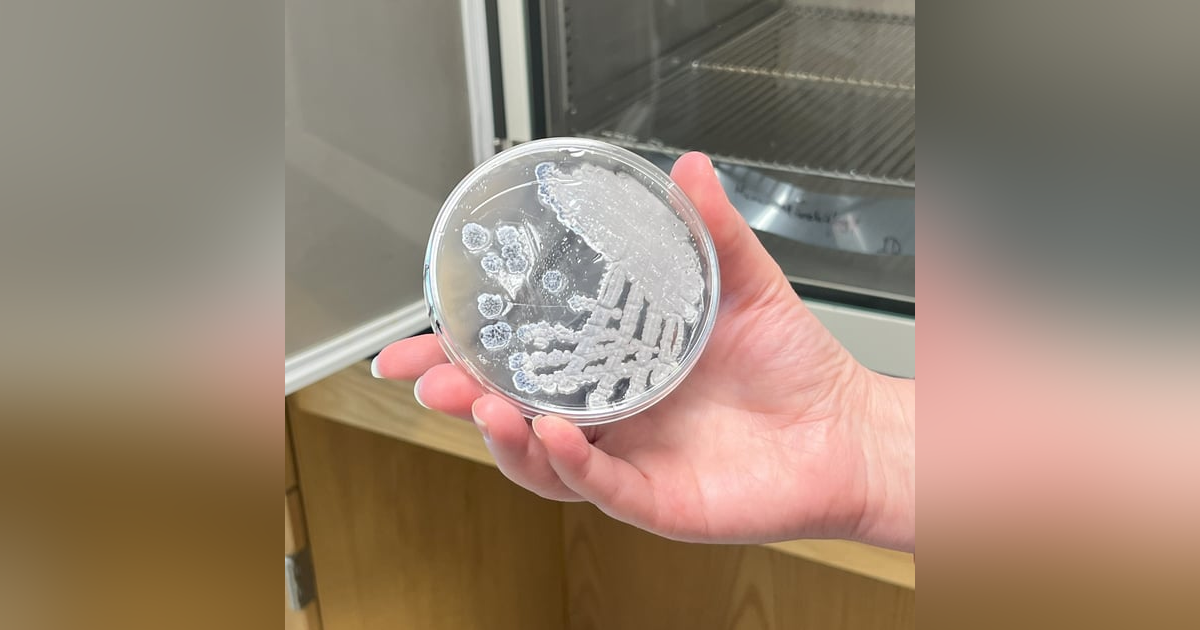
Jennifer Bennett and students, Streptomyces Jennifer Bennett and students, Streptomyces

Jan. 4, 2024
Jennifer Bennett and students, Streptomyces
Dr. Jennifer Bennett, Associate Professor and Chair of the Department of Biology and Earth Sciences talks Streptomyces research, with undergrad researchers Feng-Thea Lee and Ashni Patel, plus members of an Otterbein podcasting class assist on the interview!